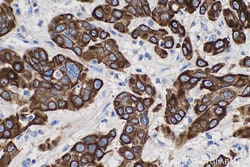
Cytokeratin 5/6 Mouse Monoclonal Antibody, Proteintech Unconjugated; 150

missing translation for 'onlineSavingsMsg'
Learn More
Learn More
Cytokeratin 5/6 Mouse Monoclonal Antibody, Proteintech
Mouse Monoclonal Antibody
Marca: Proteintech 68295-1-IG-150UL
Este artículo no se puede devolver.
Vea la política de devoluciones
Descripción
The Cytokeratin 5/6 antibody from Proteintech is a mouse monoclonal antibody generated with recombinant protein of human Cytokeratin 5/6. This antibody recognizes human, mouse, rat antigen. The Cytokeratin 5/6 antibody has been validated for the following applications: WB, IHC, IF/ICC, IF-P, ELISA analysis.Especificaciones
| Cytokeratin 5/6 | |
| Monoclonal | |
| 1000 μg/mL | |
| CK6B; K6B; KRTL1; PC2 | |
| Recombinant Protein | |
| 150 μL | |
| Primary | |
| Human, Mouse, Rat | |
| 60 kDa | |
| Liquid |
| Western Blot, Immunohistochemistry, Immunocytochemistry/Immunofluorescence, Immunofluorescence, ELISA | |
| 1F9E1 | |
| Unconjugated | |
| Mouse | |
| Protein G purification | |
| RUO | |
| 3854 | |
| Store at -20°C. Stable for one year after shipment. | |
| Monoclonal Antibody | |
| IgG1 |
Corrección del contenido de un producto
Proporcione sus comentarios sobre el contenido del producto rellenando el siguiente formulario.
Título del producto
¿Detecta una oportunidad de mejora?Comparta una corrección de contenido